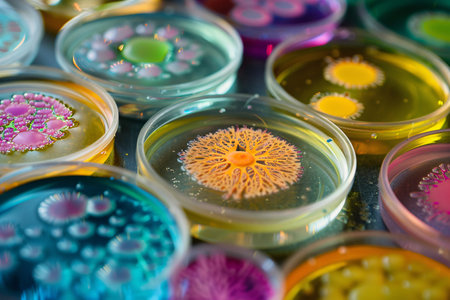
microbiology background, close up of colorful bacteria colonies in petri dishesの素材

素材 - microbiology background, close up of colorful bacteria colonies in petri dishes
作品情報
microbiology background, close up of colorful bacteria colonies in petri dishes
- ID:283076388
- 作品種別:
- 作者名:Diana Eller
キーワード
- agar
- analysis
- analyzing
- background
- bacteria
- bacteriology
- bacterium
- biochemistry
- biological
- biology
- biotechnology
- cell
- chemical
- chemistry
- clinical
- close up
- closeup
- colony
- color
- colorful
- culture
- danger
- dish
- empty
- equipment
- experiment
- fungi
- glass
- growth
- health
- healthcare
- lab
- laboratory
- medical
- medicine
- microbiology
- microscope
- petri
- petrie
- plate
- research
- sample
- science
- scientific
- technology
- test
- virus
類似作品
Backgrounds of ...
Backgrounds of ...
Paint stream dr...
Backgrounds of ...
Backgrounds of ...
Mixed of bacter...
Backgrounds of ...
Backgrounds of ...
Ink color blend...
Staphylococcus ...
Red bubbles of ...
Backgrounds of ...
Close-up blurre...
Texture of natu...
Air bubbles ins...
Backgrounds of ...
Backgrounds of ...
Staphylococcus ...
Abstract ink te...
Pink bokeh abst...
Colonies of bac...
Background with...
Yellow oil stai...
Backgrounds of ...
Abstract ink te...
Backgrounds of ...
Abstract colore...
Listeria, bacte...
epidemic and th...
Bacterial and m...
Backgrounds of ...
Fungi culture o...
Bacterial colon...
Yeast in petri ...
Ink water explo...
Mixed of bacter...
Backgrounds of ...
Backgrounds of ...
Bacterial colon...
blue mold backg...
Bacterial colon...
Microbiology La...
Backgrounds of ...
Red bubbles of ...
Backgrounds of ...
Melioidosis sic...
Yeast in petri ...
Mushroom cultiv...
Backgrounds of ...